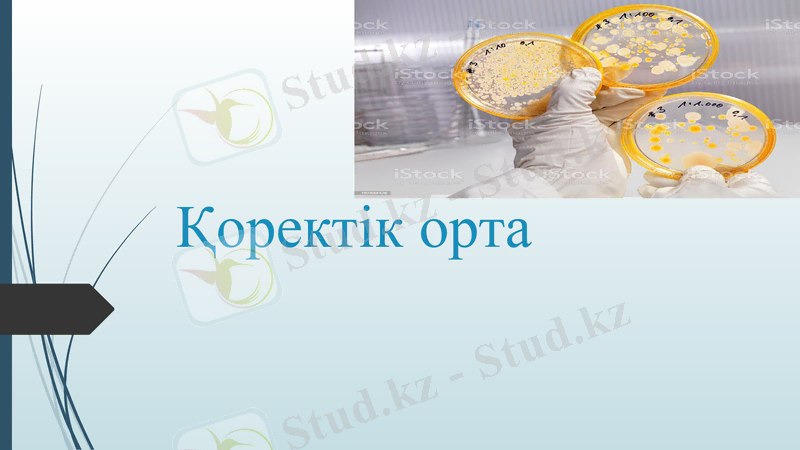
Slide 1
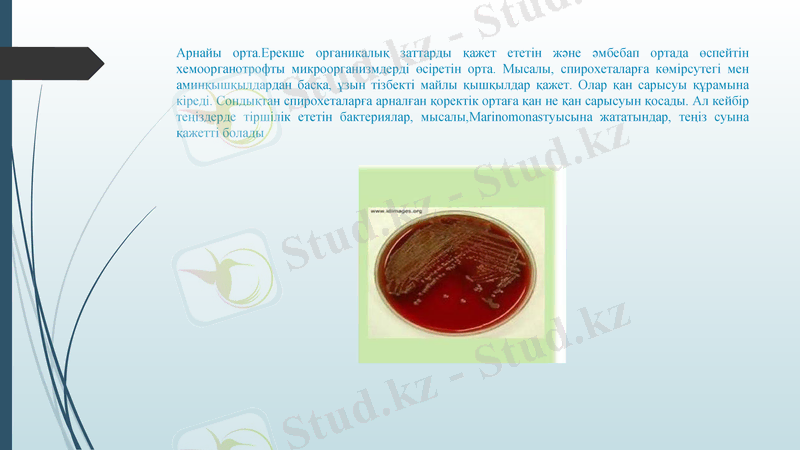
Slide 7

Қоректік орталар: түрлері, құрамы және өсімдік жасушаларын in vitro өсіру әдістемесі

Қоректік орта

Қоректік орта дегеніміз- күрделі және жай құрамдардың әртүрлі қосылыстары болып келетін орта. Оны лабораториялық жағдайда бактериялар мен басқа микроорганизмдерді көбейітіп өсіру үшін қолданылады. Қоректік ортаны жануардан немсе өсімдіктен туындаған өнімдерден дайындайды. Қоректік ортада өсу факторының болуы үлкен маңызға ие. Оларды дайындау үшін экономикалық рентабельді тағамдық емес шикізат қолданылады: жарамсыз қалған қан алмастырушылар, жануар қанының гидролизаты, , қан гидролизаты, биотехнология өнімдері - жом ашытқылары, жомдік лизин, жүзім ұнтағы, ақуыз лизин. Синтотикалық орталардың құрамына химиялық таза затрат- аминқышқылдары, минералды тұздар, көмірсулар, витаминдер және өсіру факторлары кіреді. Консистенциясы бойынша қоректік орталар сұйық, жартылай сұйық, тығыз болып келеді. Құрамы бойынша - табиғи, синтетикалық және жартылай синтетикалық.

Қоректік орталар. Құрамы
Табиғи-сүт, сарысу, жұмыртқа, ет, картоп, бұршақ, сәбіз, өсімдіктер және олардың қайнатпасы.
Жасанды- қоректік орталар арнайы рецептер бойынша дайындалады. Олар жануар текті (ЕПС, ЕПА, ЕПЖ) және өсімдік текті (сыра суслосы) болып екі топқа бөлінеді.
Синтетикалық орта деп- белгілі бір химиялық қоспалардан тұратын ортаны айтады.

Қоректік орта мына талаптарға сай болуы тиіс: бұл жерде барлық қоректік заттар жеткілікті болуы керек, тұздар, өсу факторлары, микроорганизмнің өсуіне қажетті заттардың жеңіл сіңімді түрде болуы тиіс, оптимальды ылғалдылығы, тұтқырлығы, рН-ы оптимальды стерильді болуы тиіс, мүмкіндігінше мөлдір және изотоникалы болуы тиіс. Бөгде заттар болмауы тиіс. Әрбір қоректік ортаны құрамына қарай әртүрлі әдіспен стерилизациялайды.

Пайдалану мақсатына қарай қоректік орталардың топтары негізгі 4 топқа бөлінеді:

Әмбебап қоректік орта. Бұл орталарда хемогетеротрофты, арнайы органикалық заттарды қажет етпейтін микроорганизмдердің көптеген түрлері өседі. Бұл орталарға бактериялар жақсы өсетін ет-пептонды сорпасы және ашытқы саңырауқұлақтарға лайықты сусло жатады.
Арнайы орта. Ерекше органикалық заттарды қажет ететін және әмбебап ортада өспейтін хемоорганотрофты микроорганизмдерді өсіретін орта. Мысалы, спирохеталарға көмірсутегі мен аминқышқылдардан басқа, ұзын тізбекті майлы қышқылдар қажет. Олар қан сарысуы құрамына кіреді. Сондықтан спирохеталарға арналған қоректік ортаға қан не қан сарысуын қосады. Ал кейбір теңіздерде тіршілік ететін бактериялар, мысалы, Marinomonasтуысына жататындар, теңіз суына қажетті болады

Элективті немесе таңдамалы орта. Бұл орта табиғи субстраттардан (топырақ, су, тағамдардан, өсімдік пен жануарлардан) микроорганизмдердің жеке топтарын бөліп алуға арналған. Оларды микробиологияға С. И. Виноградский енгізді. Элективті деп микроорганизмдердің белгілі бір тобының немесе түрінің өсуіне қажетті құрамы ерекше қоректік орталарды атайды. Элективті ортаны жасау барысында микроорганизмдердің физиологиясын және зат алмасуын, олардың қоректік зат көзіне талғамын, ортаның қышқылдылығын, оттектік мөлшерін, температураны және т. б жағдайларды ескеру қажет. Мысалы, азот қоспалары жоқ минералды ортада, жарық көзі бар жағдайда, молекулярлы азот сіңіруші көк жасыл балдырлар жақсы өседі. Осы ортаға қосымша органикалық энергия көзін және көміртегі көзін қосып, қараңғы жағдайда аэробты, азот сіңіруші Azotobacter-діөсіріп алуға болады. Ал осы ортада оттексіз жағдайда тежесе, анаэробты, азот сіңірушіClostridium дамиды. Құрамы әр түрлі элективті қоректік орталарды пайдаланып, түрлі фототүзуші бактерияларды бөліп алуға болады. Мысалы, күкіртті фотосинтездеуші бактерияларды бөліп алу үшін органикалық заттар жоқ қоректік ортаны пайдаланады. Ол ортада сульфидтің бар-жоғына және оның мөлшеріне байланысты әр түрлі бактерияларды бөліп алуға болады. Сонымен, органика және сульфид жоқ ортада азот сіңіретін цианобактериялар өседі. Ал осы ортаға сульфидті қосса, оның мөлшеріне қарай не жасыл, не қара-қошқыл күкіртті бактериялар өседі. Органикалық ортада қара-қошқыл күкіртті бактериялар басым болады.

Дифференциалды-диагностикалық орталар. Бұл орталарды жалпы микробиологияда әр түрлі субстраттардан бөліп алынған бактериялардың физиологиялық-биохимиялық қасиеттерін анықтап, оларды жіктеу үшін пайдаланады. Ал медициналық және ветеринарлық микробиологияда оларды ауруларды қоздыратын бактерияларды анықтау үшін қолданады. Бұл орталар бактериялардың белгілі бір ферменттерінің, мысалы, каталаза, оксидаза, протеаза, фосфотаза, желатиназа және гемолитикалық ферменттердің бар-жоғын анықтау үшін қажет. Оған қоса, дифференциалды-диагностикалық орталар бактериялардың энергия көзі ретінде қандай заттарды қай жолмен пайдаланатынын анықтауға мүмкіндік береді.

Қоректік орта дайындау
Жекеленген мүшелерді, ұлпаларды, жасушаларды және протопластарды сәтті өсірудің негізгі шарттардың бірі қатал зарасыздандыруды сақтау. Жасанды өсіруге арналған қоректік орталарда өсімдік ұлпаларда, жасушаларда микроорганизмдер жақсы дамиды да өсірілетін материалға қауіп туғызып жатады, сондықтан да мұқият зарасыздандыру өте қажет. Организмдердің тіршілік әрекеті нәтижесінде қоректік орталардың құрамы өзгереді. Одан басқа жкелеленген ұлпалар мен жасушалар протопластар ерекше тез микроорганизмдермен зақымданады. Сондықтан да барлық зертханалық жұмыстар жекелеген мүшелер, жасушаларн мен ұлпалар және өсімдік протопластары бойынша ламинар - бокстарда өткізіледі. Жұмысқа қажетті барлық материалдар, мақта пробкалары, қоректік орталар, өсімдік материалдар, ыдыстар, инструменттерді және боксты зарасыздандырылады.
Шоғырланған жасушалар мен ұлпаларды өсіруге арналған қоректік орталарда өсімдіктерге қажетті барлық макроэлементтер, дәрумендер, көмірсулар, фитогормондар болуы тиіс. Кейбір қоректік орталарда гидролизат казеині мен белгілі бір аминқышқылдар болады. Осыдан басқа қорктік орталардың құрамына ЭДТА ( қышқылы) немесе оның натрий тұзы жасушаларға темірді жеткізуге белгілі бір рН болады. Шоғырланған ұлпалар мен жасушаларды өсіру кезінде қоректік орталарда қажетті компоненттің бірі көмірсулар болып саналады, себебі олар автотрофты қоректенуге қабілетсіз болады. Әдетте көмірсулар көзі ретінде сахароза немесе глюкозаны 20 - 40 г/л концентрациясында қолданады. Жасушалар дифференциясы және жасушалық бөліну индукциялары үшін өсу реттеушілер қажет. Сондықтан да калустық ұлпаларды алу үшін қоректік орталардың құрамына жасушаның дедифференцировканы тудыратын аусиндер мен цитокиндер кіруі керек.

Қоректік орта дайындау
Әдетте қоректік орталарда ауксиндердің көзі ретінде 2, 4 дихлрфиноксисірке қышқылын (2, 4-Д), 1 - 10 мг/л; индолилсірке қышқылын (ИСҚ) (ИУК) 1 - 30мг/л және нафтилсірке қышқылын (НСҚ) - 0, 1 - 2 мг/лпайдалынады (ИСҚ) 2, 4 Д қарағанда 30 есе аздау болады. Каллус пайда болу индукциясына әдетте ауксиндердің жоғары концентрациясын пайдаланады, ал кейінгі көшіріліп отырғызу кезінде ұлпа өседі де ортадағы ауксиндердің құрамы бірнеше есе азайтлады.
Жасанды қоректіе қоспаларда цитокиндердің көзі ретінде кинетин 6 - бензилалинопурин (6-БАП), зеатин (0, 001 - 10 мг/л) кинетинге қарағанда зеатин мен БАП шоғырланған ұлпалардың өсуін және органогенез индукциясын реттеуде белсендірек болады. Кейбір қорктік қоспалардың құрамына аденин кіреді.
Жеке қоректік орталарда ауксин мен цитокиндерден басқа гибберел қышқылы да (ГҚ) болады. Кейбір жағдайларда қорктік орталарға өсімдік экстрактылары мен шырындарын қосады. Өсуін ең белсендіргіш қасиеттке кокос мен сұйық кокос жаңғағының сұйық эндоспермі ие
Қатты қоректік орталарды дайындау үшін теңіз балдырлардан алатын агар - агар полисарид пайдалынады. Әдетте қатты қоректік қоспаны алу үшін ортаға 5 - 8 % қосады.
Макротұздардың микротұздардың және дәрумендердің ерітінділерін концентрленген түрде дайындау ыңғайлы. Маточный ерітінділерді тоңазытқышта, ал дәрумендерді теріс температурада сақтау керек.
Макротұздардың ерітінділерін 10 - 20 есе концентірленген, микротұздардың 100 - 1000 есе болса, ал дәрумендердің ерітінділері 1000 есе концентрленген болып дайындау керек.
Жасушаларды, ұлпаларды және өсімдіктердің белгілі бір мүшелерін өсіру үшін қоректік орталардың әр түрлі құрамын қолданады.

Өсімдіктердің жасушаларын, ұлпаларын және мүшелерін қолдан өсіру сәтті шығу үшін жасанды органың құрамының жақсы болуымен қатар әртүрлі қолайлы жағдайлар жасалуы қажот. Осы айтылған сөзге жасушаны қолдан өсіру сәтті болуы үшін үнемі температура шамамен 25±2°С болуы қажот деп жалпылай қабылданған шешім дәлел болады. Алайда мұндай дәстүрлі тәсіл ақпараттың аздығынан қолданылған болатын. Өйткені темекінің каллусының өсуіне 32°С, кәдімгі гармалаға 30°С, ипомеяға 30-32°С қажот.

Өсімдіктерді өсіруге қажетті қоректік орта
Өсімдіктерді өсіруге қажетті қоректік орта (Мурасиге - Скуга) Қазіргі кезде өсімдік жасушалары мен ұлпаларын өсіруге айтарлықтай көп көңіл бөлінуде. In vitro жағдайында өсімдіктерді өсіру іргелі реттеулер болып табылатын өсімдіктер генетикасы, физиологиясы, цитологиясы және молекулярлық биология сияқты ғылым салаларын дамыта отырып ауылшаруашылығы дақылдарының өнімділігін жоғарлатып, сапасын көтеруде маңызды роль атқарады. Өсімдік шаруашылығы бүтін өсімдіктерді өсіріп көбейтеді, ал өсімдіктер биотехнологиясында істелінетін жұмыстар жасанды қоректік ортада өсетін өсімдік материалдарын (жасушалар, ұлпалар, мүшелер) пайдалануға негізделген. Зерттеліп жатқан нысандарға сипаттама: Өсімдіктер биотехнологиясының негізгі нысандары, ол тұтас өсімдіктерден оқшауланып алынған жасанды қоректік ортада асептикалық жағдайда өсірілерін жеке жасушалар, ұлпалар және өсімдік мүшелері. Өсімдік жасушалары іn vitro жағдайында қайтадан эмбриондық күйіне айналып, тұтас өсімдіктерге бастама бола алады, олардың бір қалыпты өсуге, гүлдеуге және ұрпақ беруге қабілеті бар. Қоректік ортада өскен өсімдік жасушаларының осындай ғажайып қасиетін тотипотенттілік деп атайды. Бұл құбылыс қазір биотехнологияда селекция жұмыстарын тездету мен жеңілдету және өсімдіктерді көбейту үшін табысты түрде қолданылуда. Тағы да ескеретін жағдай, ол жасушаларды жасанды ортада өсіру әдісі, дағдылы селекция әдістеріне қарағанда генетикалық жағынан өзгерген өсімдіктерді тез алуға мүмкіндік жасайды. Жасушаларды жасанды ортада өсіру әдістері алдымен генетикалық базисті кеңейтіп селекцияның тиімділігін арттырады.

М. Бейеринк ұсынған жинақ орта
Жинақ ортаны М. Бейеринк ұсынды. Мұндай орталарда қандай да бір компонент артық мөлшерде болады. Сонда сол компонетті пайдаланатын микроорганизмдер өседі, яғни олар доминантты болады. Бұл орталарды табиғи субстратта саны аз бактерияларды бөліп алу үшін қолданады. Жинақ және элективті орталарды қолдану әдістері ұқсас болса да, олардың арасында айырмашылықтар да бар. Элективті орталарды қолданғанда, зерттейтін сынамаларды тікелей тығыз қоректік ортаға егіп, колонияларды бөліп алады. Ал жинақ орталарды қолданғанда, оларды, алдымен, сұйық ортада өсіріп алып, содан кейін тығыз қоректік ортаға егеді.

Өсімдік жасушалары мен ұлпаларын in vitro жағдайында өсіру үшін сұйық және агар (қатты) орталар қолданылады. Агар орталары рН 5, 6 - 6, 0 сумен гель түзетін теңіз балдырларының құрамына кіретін полисахарид - агар-агар негізінде дайындалады. Әдетте ортаға 0, 7-0, 8% агар қосады. Кейде полиакриламидті гельдер (биогельдер) агар-агарды тығыздағыш және алмастырғыш ретінде пайдаланады. Көптеген қоректік орталар жасалған, бірақ олардың көпшілігі негізгілерінің модификациялары: Мурашиге-Скоог (МС), Уайт, Гамбург (В5), Чапек және т. б. Жасанды қоректік орталар үшін макро- және микротұздардың ерітінділері дайындалады. ілгерілетіп, бірнеше рет пайдаланылады. Бұл аналық (концентрлі) ерітінділер. Олар ерекше жағдайларда сақталады: макро- және микро-тұздар тоңазытқышта ұнтақталған тығыны бар ыдыстарда 0 - +4 ° C температурада. Витаминдер, фитогормондар, ферменттер, өсімдік сығындылары -20 ° C температурада тығындары бар 5-10 мл шағын ыдыстарда жақсы сақталады. Макротұздардың аналық ерітінділері әдетте концентрациясы бойынша жұмыс істейтіндерден 10-40 есе, микротұздар - 100-1000 есе, витаминдер - 100 есе артық. Макро- және микротұздардың қоймалық ерітіндісін дайындау үшін әрбір тұзды қыздырған кезде бөлек стаканға ерітеді, содан кейін суды ағызып, қажетті көлемге келтіреді

Салқындатылған микротұздар қоспасына ең соңында молибден тұздарының ерітіндісін қосады, ал макротұздарға магний тұздарының ерітіндісін қосады (тұндырудың алдын алу үшін) . Темір хелатының, сондай-ақ кальций хлоридінің (CaCl2) аналық ерітіндісі басқа тұздардан бөлек дайындалады және сақталады. Хелатталған темірді дұрыс емес дайындау автоклавтан кейін кальций мен магний фосфатының тұнбаға түсуіне әкелуі мүмкін. Витаминдердің концентрлі ерітінділерін дистилденген суда тиісті салмақтарды (немесе ампулаларды) еріту арқылы бөлек дайындайды. Фитогормондар, әдетте, суда нашар ериді. Ауксиндер мен гиббереллиндерді алдымен аз мөлшерде этил спиртінде ерітеді, содан кейін дистилденген сумен қажетті көлемге келтіреді. Цитокининдерді алдымен аз мөлшерде 0, 5-1 н NaOH немесе KOH ерітіндісінде ерітеді, содан кейін су моншасында толық ерігенше қыздырып, дистилденген сумен қажетті көлемге жеткізеді. Макротұздардың, микротұздардың, фитогормондардың және витаминдердің ерітінділерін сақтау үшін зарарсыздандырылған ыдыстарды қолданған жөн. Ортаның рН мәні маңызды. Қоректік ортаның бірқатар компоненттерінің тұрақтылығы мен сіңімділігі рН мәніне байланысты. ХАА, гибберел қышқылы, витаминдер рН-ға ең сезімтал. Төмен рН (қышқыл) жағдайында агар қатпайды. Тіндерді өсіру үшін темір қосылыстарының болуы рН-ға да байланысты. Оқшауланған өсімдік ұлпаларының дақылдарының көпшілігі рН 5, 5 - 5, 8 болатын орталарда өседі.

Дайындық кезеңі.
1. Бөлмені жұмысқа дайындаңыз - жуғыш заттарды пайдаланып мұқият дымқыл тазалауды орындаңыз.
2. Бөлмені 1, 5 - 2 сағат кварцтау. Кварцтау кезінде бөлмеге кіруге (қалуға) тыйым салынады! Шамға қорғаныс көзілдірігінсіз қарамаңыз! Кварцтау аяқталғаннан кейін (УК шамын өшіру), 10-15 минут күтіңіз.
3. Таза стерильді ыдыстар мен құралдарды дайындаңыз.
4. Жұмыс алдында бірден ламинардың ішкі беттерін этил спиртінің 70% ерітіндісімен сүрту керек, оған қажетті құралдар мен материалдарды: герметикалық ыдысқа спирт, спирт шамы (оттық), сіріңке, зарарсыздандырылған құралдар мен ыдыс-аяқ.
5. Өсімдік материалымен барлық манипуляциялар қораптың стерильді бетінде немесе стерильденген Петри табақшаларында спирт оттығының жалынында орындалуы керек.
6. Құралдармен жұмыс істегенде, әрбір манипуляция алдында оларды (скальпель, кесетін ине, пинцет және т. б. ) спирті бар стаканға салып, содан кейін оларды оттық жалында күйдіріңіз. Әрбір манипуляция құралы бір рет қолданылады!

2. Кезең:
1. Макро- және микроэлементтердің, витаминдердің, өсу реттегіштерінің қор ерітінділерін дайындаңыз.
2. 1 л ортаны 1 литрлік стаканға дайындау үшін пипеткамен бастапқы ерітінділердің әрқайсысының қажетті көлемін құйыңыз.
3. Мезо-инозитолды, глицинді, сахарозаны аз мөлшерде тазартылған суда (әрқайсысы бөлек) ерітіп, алынған ерітінділерді аналық ерітінділері бар стаканға қосыңыз.
4. Алынған сұйық қоректік ортаны стаканнан өлшеуіш цилиндрге құйып, дистилденген сумен 950 мл-ге дейін жеткізіңіз.
5. Ортаның рН мәнін қажетті мәнге жеткізіңіз. Егер рН қажетті мәннен жоғары болса, бірнеше тамшы 1Н HCl қосыңыз, егер ол осы мәннен төмен болса, градуирленген цилиндрге бірнеше тамшы 1Н NaOH (KOH) қосыңыз, мұқият араластырыңыз. Ортаның аз көлемін стақанға құйыңыз, рН өлшеңіз. Ортаның рН-ын қажетті мән орнатылғанша өлшеңіз.
6. Табақшалы агардың өлшенген мөлшерін (6-7 г) қоректік ортасы бар стаканға салады, үнемі араластыра отырып, пеште қыздырып (қайнатпай) ерітеді.
- Іс жүргізу
- Автоматтандыру, Техника
- Алғашқы әскери дайындық
- Астрономия
- Ауыл шаруашылығы
- Банк ісі
- Бизнесті бағалау
- Биология
- Бухгалтерлік іс
- Валеология
- Ветеринария
- География
- Геология, Геофизика, Геодезия
- Дін
- Ет, сүт, шарап өнімдері
- Жалпы тарих
- Жер кадастрі, Жылжымайтын мүлік
- Журналистика
- Информатика
- Кеден ісі
- Маркетинг
- Математика, Геометрия
- Медицина
- Мемлекеттік басқару
- Менеджмент
- Мұнай, Газ
- Мұрағат ісі
- Мәдениеттану
- ОБЖ (Основы безопасности жизнедеятельности)
- Педагогика
- Полиграфия
- Психология
- Салық
- Саясаттану
- Сақтандыру
- Сертификаттау, стандарттау
- Социология, Демография
- Спорт
- Статистика
- Тілтану, Филология
- Тарихи тұлғалар
- Тау-кен ісі
- Транспорт
- Туризм
- Физика
- Философия
- Халықаралық қатынастар
- Химия
- Экология, Қоршаған ортаны қорғау
- Экономика
- Экономикалық география
- Электротехника
- Қазақстан тарихы
- Қаржы
- Құрылыс
- Құқық, Криминалистика
- Әдебиет
- Өнер, музыка
- Өнеркәсіп, Өндіріс
Қазақ тілінде жазылған рефераттар, курстық жұмыстар, дипломдық жұмыстар бойынша біздің қор #1 болып табылады.



Ақпарат
Қосымша
Email: info@stud.kz